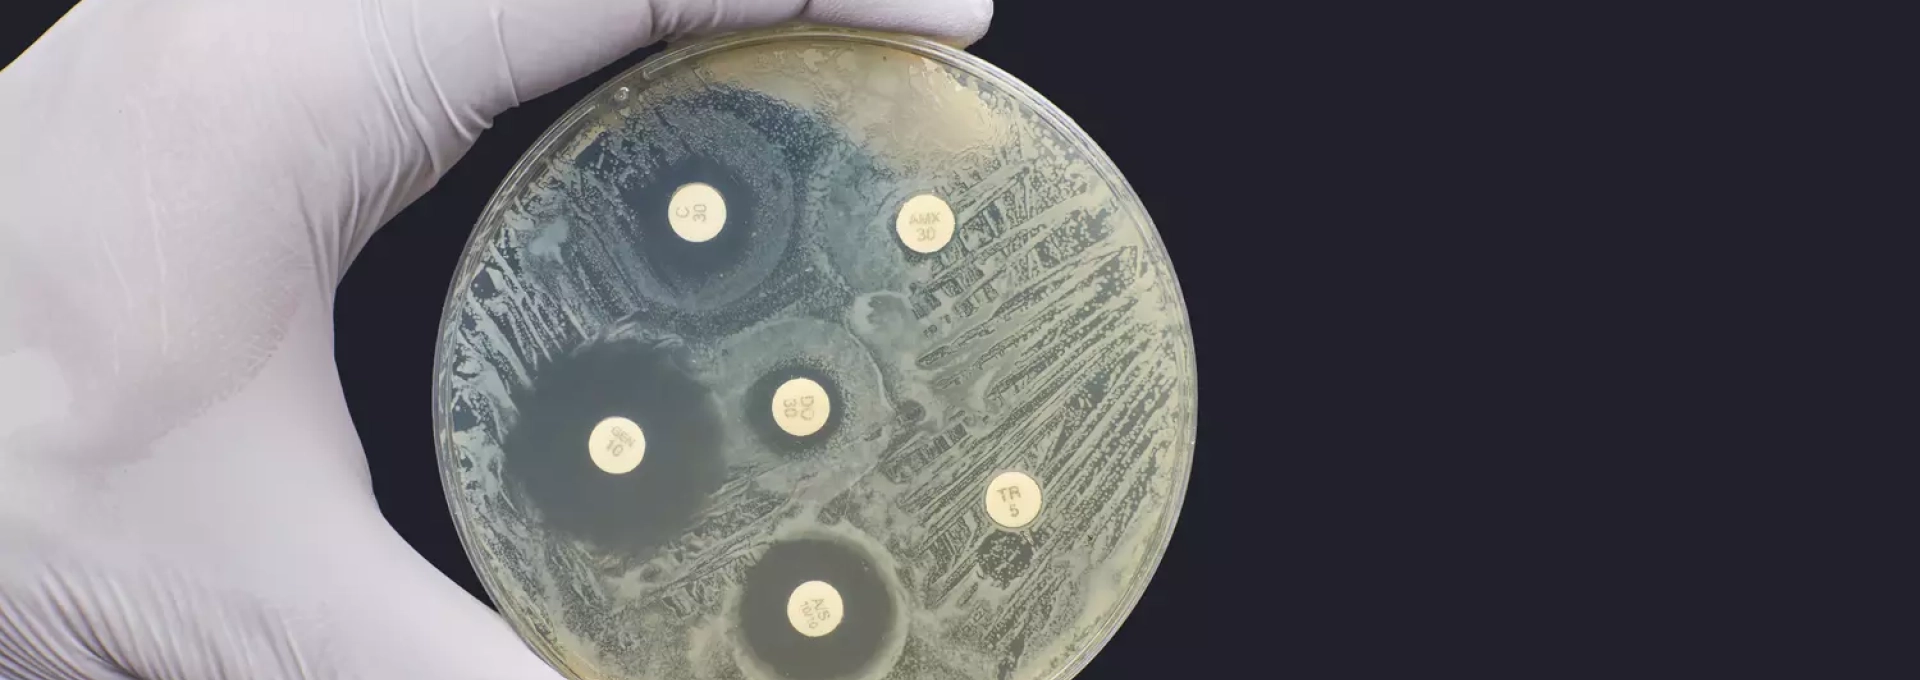

L’antibiogramme est un outil fondamental en microbiologie clinique, permettant d’optimiser le traitement des infections bactériennes. Cette technique, développée il y…
Lire la suite
Dans le monde de la recherche scientifique et des analyses médicales, la qualité du matériel de laboratoire joue un rôle…
Lire la suite
L’industrie pharmaceutique est soumise à de nombreuses réglementations strictes et les produits pharmaceutiques doivent être produits et stockés dans des…
Lire la suiteLa révolution silencieuse des thérapies géniques transforme radicalement le paysage des soins pour les maladies rares. En déployant des solutions…
Lire la suiteLa médecine du futur s’annonce radicalement différente grâce au potentiel sans précédent de l’ingénierie tissulaire. Imaginez une ère où les…
Lire la suiteLa bio-impression 3D, une percée technologique bouleversante, ouvre d’incroyables perspectives pour la médecine régénérative. Sa promesse ? Créer sur mesure…
Lire la suiteL’harmonie entre la science et la nature n’est plus une idée romanesque, mais un domaine d’étude et d’innovation émergent connu…
Lire la suite